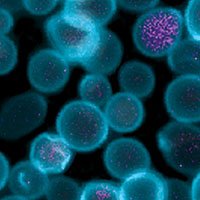

Safeguarding Biological Evolution from GMOs 2.0
WATCH THE 16 MINUTE FILM:
Our Allies
















































Problem:
Unprecedented Threat to Nature’s Gene Pool
We face the unprecedented threat of the widespread corruption and replacement of nature’s gene pool. In the U.S., gene-edited organisms can be released into the environment without any assessments.
GENETICALLY MODIFIED ECOSYSTEMS
A farm will be able to order custom engineered insects, seeds, soil microbiomes, and pesticide sprays.
GENE DRIVE
A new gene is forced through future generations of an entire species, changing its DNA and even wiping it out.
INSECTS THAT DELIVER VIRUSES
The U.S. Department of Defense is developing insects with viruses that infect and alter plants.
AI MEETS BIOTECH
Biotech driven by artificial intelligence will create more and invasive changes on a massive scale.
- All these efforts are prone to calamitous and uncontrollable side effects.
Solution:
Our Protect Nature Now Campaign
With the pandemic, the world is now acutely aware of how a single virus - a microbe - can wreak havoc.
Unlike GMO crops, which are well established in many countries, GE (Genetically Engineered) microbes have not been widely deployed yet. Our Protect Nature Now campaign will initially focus on containing GE microbes—and we stand ready to address other emerging threats as they arise.
Governments and civil society are largely unaware and wholly unprepared to manage the threat of these and other next generation applications known as GMO 2.0.
To learn more about Protect Nature Now please click here.
GMO 2.0
GMO 2.0 refers to the new genetic modification techniques that allow corporations to create GMOs more cheaply, easily, and quickly than ever before. They can tamper with nature by editing genes, changing species and creating entirely new DNA sequences. The results of these risky and unregulated processes are wildly unpredictable.
Our Mission Statement
The mission of Protect Nature Now is to raise public awareness, generate political urgency around regulations, and build global opposition to the release of genetically modified microbes. Our efforts will lead to a moratorium on this work, comprehensive risk analysis, and binding international policies to protect nature’s gene pool. To find out more details click here
JOIN the movement NOW
The decisions we make now determine whether future generations inherit the offspring of billions of years of evolution, or the products of unregulated laboratory techniques that pose unknown dangers.
The existential threat posed by the mass release of GMOs demands that humanity looks at itself and nature through a new lens. As our technologies widen in their impact, so too must our awareness and care. We must consciously and carefully steward the evolution of all living beings through future generations.
We hope that you join us in Protecting Nature Now. Your contribution is vital to our success. With your support, we will be able to control this global threat.